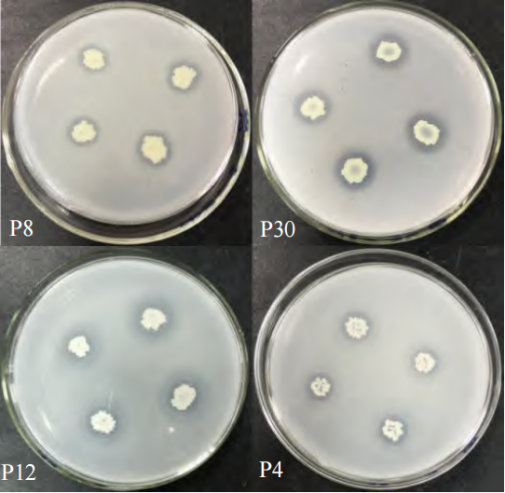

望天树(Parashorea chinensis)是龙脑香科(Dipterocarpaceae)柳安属植物,是我国特有的一级濒危树种、热带雨林的标志树种和珍贵乡土树种,具有很高的科学价值和经济价值。大面积的过度开发使其天然群落遭受破坏,生境破碎化,天然更新困难。望天树人工育苗和人工林培育是拯救其濒危现状、扩大其种群数量的重要途径。然而,在人工栽培过程中,研究人员发现望天树存在种子成苗率低,幼苗死亡率高、苗期根系发育慢、幼树生长迟缓等难题。
为解决上述望天树人工栽培过程中遇到的难题,杨梅教授团队分别从苗木抗逆性、菌肥促生效果评价、人工林土壤养分特征和微生物多样性,以及人工林土著溶磷促生菌筛选等方面对望天树展开了长期且不断深入的研究,取得了以下阶段性进展:
一:望天树苗木的抗寒性及其对不同芽孢杆菌菌剂的响应研究
望天树幼苗抗寒性研究结果表明:望天树苗期叶片在0 ℃低温胁迫中受到一定程度的伤害,0 ℃处理2 d可作为早期筛选耐寒材料的时间节点;待温度回升到25 ℃后,渗透调节物质含量及抗氧化酶活性开始下降,表明望天树幼苗在遭受低温胁迫后具有一定的自我修复能力。低温触发了望天树幼苗的抗冷机制,促使望天树幼苗主动积累可溶性糖、可溶性蛋白,降低细胞渗透势,缓减了望天树幼苗因低温而导致的细胞失水,一定程度上减轻了望天树幼苗的低温伤害。

注:A.低温0℃处理0d后植株叶片症状;B.低温0℃处理1d后植株叶片症状;C.低温0℃处理2d后植株叶片症状;D.温度回升到25℃后植株叶片症状。
图1 低温处理后植株叶片症状
望天树幼苗接种3种芽孢杆菌研究结果表明:3种菌剂对苗木的生长和光合作用均有促进作用,苗高、地径增量分别较对照提高了30.2%~57.2%和5.3%~49.7%,根系活力提高了74.5%~227.4%,净光合速率提高了15.3%~227.6%。巨大芽孢杆菌(Bacillus megaterium)处理下的苗木生长、生物量、根形态、叶光合效率、光化学淬灭系数均表现最好,对望天树苗木生长发育的促进作用最大。(该研究结果以“3种芽孢杆菌菌剂对望天树苗木生长和光合特性的影响”为题发表在《热带亚热带植物学报》上,2019级硕士研究生汪丛啸为该论文的第一作者,杨梅教授为通讯作者。该研究获得国家自然科学基金项目(31960307),以及广西自然科学基金项目(2018GXNSFAA28110)共同资助)。
二:望天树人工林土壤养分特征及其生态化学计量比研究
土壤微生物量碳氮和养分特征研究结果表明:望天树人工林土壤养分含量随着土层深度的加深而下降,不同林分类型(混交林和纯林)对养分垂直分布格局影响不明显;望天树纯林改造为混交林可以改善种植区域的土壤养分状况,提高土壤微生物量碳、氮含量,在一定程度上促进了土壤微生物的活动。望天树和巨尾桉混交可以明显提高土壤微生物活性,改善土壤质地和微环境。土壤微生物量碳、氮可以灵敏地反映林地土壤质量、肥力状况以及林分改造过程中产生的变化,可作为土壤养分储备库和碳氮源变化的早期生物指示指标。(该结果以“望天树人工幼林土壤微生物量碳氮及养分特征”为题发表在《北京林业大学学报》,2021级博士研究生李万年为该论文的第一作者,杨梅教授为通讯作者。该研究获得国家自然科学基金项目(31960307),以及广西自然科学基金项目(2018GXNSFAA28110)共同资助)。
土壤养分、微生物量和酶的生态化学计量比研究结果表明:亚热带望天树林地土壤均不同程度地受到土壤C、N、P的限制。土壤养分含量、微生物量和酶活性以及它们之间的生态化学计量比在根际和非根际间存在显著差异,对林龄变化敏感。根际和非根际土壤P限制是望天树及其林地土壤微生物在生长发育过程中共同面临的养分缺乏难题,维持较高含量的铵态N、硝态N、速效P和速效K等有效养分含量的是缓解养分限制的关键因子。P有效性在望天树生长和林地根际微生物群落构建方面发挥着关键作用。(该结果以“Soil C, N, P, K and Enzymes Stoichiometry of an Endangered Tree Species,Parashorea chinensisof Different Stand Ages Unveiled Soil Nutrient Limitation Factors”为题发表在《Forests》,2021级博士研究生李万年和巴基斯坦籍博士后Izhar Ali为该论文的第一作者,杨梅教授为通讯作者。该研究获得国家自然科学基金项目(31960307),广西研究生教育创新计划(YCBZ2022036),以及广西自然科学基金项目(2018GXNSFAA28110)共同资助)。

图2不同林龄下根际和非根际土壤养分化学计量比

图3不同林龄下根际和非根际土壤微生物量的化学计量
三:望天树人工林土壤微生物群落特征及其功能多样性研究
土壤微生物群落特征研究结果表明:3种林分(望天树纯林(WC)、望天树×降香黄檀混交林(WJ)和望天树×尾巨桉混交林(WA)),根际土壤微生物总PLFA及细菌、真菌、放线菌的PLFA含量均表现为WA>WJ>WC;土壤理化性质(包括含水量、pH值、有机质、全氮、全钾、硝态氮、铵态氮、速效钾含量及蔗糖酶、脲酶和酸性磷酸酶活性)与微生物特征(即代谢活性、功能多样性指数及PLFA含量)均存在显著正相关关系。从土壤理化性质及微生物群落功能和结构特征分析来看,3种林分中望天树×尾巨桉是最有利于改善望天树幼树期土壤微生态环境、提高土壤可利用养分的混交模式。(该结果以“望天树人工林根际土壤理化性质及微生物群落特征”为题发表在《应用生态学报》,2022级博士研究生韩小美为该论文的第一作者,杨梅教授为通讯作者。该研究获得国家自然科学基金项目(31960307),以及广西自然科学基金项目(2018GXNSFAA28110)共同资助)。
土壤微生物群落功能多样性研究结果表明:望天树×巨尾桉混交林的土壤微生物功能多样性指数Shannon-Wiener、Simpson和McIntosh均最高,显著高于纯林;混交林的土壤微生物对碳源的利用能力和代谢活性及微生物数量高于纯林,且随土层加深而下降;土壤微生物对酚酸类碳源的利用程度最高、胺类次之、多聚物最低,混交林和纯林分别对氨基酸类、羧酸类碳源的依赖度更高;土壤pH、有机质、全K和速效K含量是造成混交林和纯林间,及不同土层间土壤微生物功能多样性和碳源利用存在差异的关键驱动因子。(该研究结果以“望天树人工幼林混交对土壤微生物功能多样性与碳源利用的影响”为题发表在《植物生态学报》,2021级博士研究生李万年为该论文的第一作者,杨梅教授为通讯作者。该研究获得国家自然科学基金项目(31960307),广西自然科学基金项目(2018GXNSFAA28110),以及广西研究生教育创新计划(YCBZ2022036)共同资助)。

注:MPD,望天树和降香黄檀混交林; MPE,望天树和巨尾桉混交林; PP,望天树纯林。C1,碳水化合物类; C2,氨基酸类; C3,羧酸类; C4,多聚物类; C5,酚酸类; C6,胺类。AK,速效钾含量; AP,速效磷含量; NO3–-N,硝态氮含量; pH,酸碱度; SOM,土壤有机质含量; TK,全钾含量; TN,全氮含量; TP,全磷含量。
图4 土壤微生物群落碳源利用与环境因子的冗余分析(RDA)
四:望天树人工林根际土壤溶磷细菌筛选及其溶磷特性研究
研究结果表明:从3个不同林龄(1、2和41年)望天树人工林根际共分离筛选出18株溶磷菌,其中溶磷能力较强菌株为P4、P8、P12和P30;结合各菌株的菌落特征、生理生化特征、16S rDNA序列的比对结果和系统发育树的分析,将P4菌株和P12菌株鉴定为洋葱伯克霍尔德菌(Burkholderia cepacia),P8菌株为唐菖蒲伯克霍尔德菌(Burkholderia gladioli),P30菌株为蜡状芽孢杆菌(Bacillus cereus)。4株溶磷菌株在30~35℃,pH为5.5~8.5,NaCl质量分数为0~2.5%时均具有良好的溶磷能力,对磷酸铝和磷酸铁的溶磷量均达300 mg/L,菌株对温度和pH的耐受性较广,在南方酸性土壤具有较大的应用潜力,有望作为望天树专用溶磷菌肥研制的优质菌株。筛选得到的4株高效溶磷菌具有良好的溶磷能力,且能够溶解多种难溶性无机磷酸盐,可用于望天树专用微生物肥料的研发,具有良好的应用潜力。(该研究结果以“望天树人工林根际溶磷细菌的筛选及溶磷特性”为题发表在《北京林业大学学报》,2020级硕士研究生韦双为该论文的第一作者,杨梅教授为通讯作者。该研究获得国家自然科学基金项目(31960307),以及广西自然科学基金项目(2018GXNSFAA28110)共同资助)。
图5部分溶磷细菌溶磷圈

图6溶磷细菌系统发育树
根据前期的调查研究和试验发现,望天树在幼苗时根系生长缓慢,侧根不发达,进而使其在幼苗时期生长迟缓,抵抗力弱,死亡率高,磷素对根系的生长发育至关重要,解磷微生物是提高土壤有效磷的主要途径,所以从望天树人工林中分离、筛选高效解磷细菌,是解决望天树苗期和幼树根系发育迟缓、生长缓慢的问题的有效办法。因此,杨梅教授团队从上述溶磷细菌中挑选既能溶解有机磷,又能溶解无机磷的高效功能菌,成功申请了国家发明专利。从而可提供一种唐菖蒲伯克霍尔德菌(Burkholderia gladioli)P8,用于将土壤中难溶性的磷转化为可以被植物吸收的有效磷。该菌株现保藏于中国微生物菌种保藏中心管理委员会普通微生物中心(简称CGMCC),保藏登记号为CGMCC No.22825。(该成果以“一株唐菖蒲伯克霍尔德菌P8及其应用”为发明名称获得国家知识产权局授予的专利权。发明人:杨梅、韩小美、余注光、黄平升、李万年、汪丛啸、廖思。专利号:ZL 2021 1 1531315.5)。

图7发明专利证书